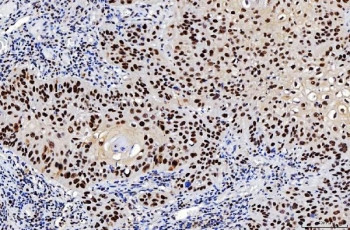
Anti-FEN1 / Flap endonuclease 1, clone 6F3F2

Cookie preferences
This website uses cookies, which are necessary for the technical operation of the website and are always set. Other cookies, which increase the comfort when using this website, are used for direct advertising or to facilitate interaction with other websites and social networks, are only set with your consent.
Configuration
Technically required
These cookies are necessary for the basic functions of the shop.
"Allow all cookies" cookie
"Decline all cookies" cookie
CSRF token
Cookie preferences
Currency change
Customer-specific caching
FACT-Finder tracking
Individual prices
Selected shop
Session
Comfort functions
These cookies are used to make the shopping experience even more appealing, for example for the recognition of the visitor.
Note
Show the facebook fanpage in the right blod sidebar
Statistics & Tracking
Affiliate program
Conversion and usertracking via Google Tag Manager
Track device being used
| Item number | Size | Datasheet | Manual | SDS | Delivery time | Quantity | Price |
|---|---|---|---|---|---|---|---|
| NSJ-RQ6987 | 100 µg | - | - |
3 - 10 business days* |
790.00€
|
If you have any questions, please use our Contact Form.
You can also order by e-mail: info@biomol.com
Larger quantity required? Request bulk
You can also order by e-mail: info@biomol.com
Larger quantity required? Request bulk
0.5mg/ml if reconstituted with 0.2ml sterile DI water. Flap endonuclease 1 is an enzyme that in... more
Product information "Anti-FEN1 / Flap endonuclease 1, clone 6F3F2"
0.5mg/ml if reconstituted with 0.2ml sterile DI water. Flap endonuclease 1 is an enzyme that in humans is encoded by the FEN1 gene. It is mapped to 11q12.2. The protein encoded by this gene removes 5' overhanging flaps in DNA repair and processes the 5' ends of Okazaki fragments in lagging strand DNA synthesis. Direct physical interaction between this protein and AP endonuclease 1 during long-patch base excision repair provides coordinated loading of the proteins onto the substrate, thus passing the substrate from one enzyme to another. The protein is a member of the XPG/RAD2 endonuclease family and is one of ten proteins essential for cell-free DNA replication. DNA secondary structure can inhibit flap processing at certain trinucleotide repeats in a length-dependent manner by concealing the 5' end of the flap that is necessary for both binding and cleavage by the protein encoded by this gene. Therefore, secondary structure can deter the protective function of this protein, leading to site-specific trinucleotide expansions. Protein function: Structure-specific nuclease with 5'-flap endonuclease and 5'- 3' exonuclease activities involved in DNA replication and repair. During DNA replication, cleaves the 5'-overhanging flap structure that is generated by displacement synthesis when DNA polymerase encounters the 5'-end of a downstream Okazaki fragment. It enters the flap from the 5'-end and then tracks to cleave the flap base, leaving a nick for ligation. Also involved in the long patch base excision repair (LP-BER) pathway, by cleaving within the apurinic/apyrimidinic (AP) site- terminated flap. Acts as a genome stabilization factor that prevents flaps from equilibrating into structures that lead to duplications and deletions. Also possesses 5'-3' exonuclease activity on nicked or gapped double-stranded DNA, and exhibits RNase H activity. Also involved in replication and repair of rDNA and in repairing mitochondrial DNA. [The UniProt Consortium]
| Keywords: | Anti-MF1, Anti-RAD2, Anti-FEN-1, Anti-hFEN-1, Anti-DNase IV, Anti-Flap endonuclease 1, Anti-Maturation factor 1, Anti-Flap structure-specific endonuclease 1, FEN1 Antibody / Flap endonuclease 1 |
| Supplier: | NSJ Bioreagents |
| Supplier-Nr: | RQ6987 |
Properties
| Application: | WB, IHC (paraffin), IF, FC |
| Antibody Type: | Monoclonal |
| Clone: | 6F3F2 |
| Conjugate: | No |
| Host: | Mouse |
| Species reactivity: | human, mouse, rat |
| Immunogen: | Recombinant human protein (amino acids Q4-E300) |
| Format: | Apoptosis, Cell Cycle, DNA Repair |
Database Information
| KEGG ID : | K04799 | Matching products |
| UniProt ID : | P39748 | Matching products |
| Gene ID : | GeneID 2237 | Matching products |
Handling & Safety
| Storage: | +4°C |
| Shipping: | +4°C (International: +4°C) |
Caution
Our products are for laboratory research use only: Not for administration to humans!
Our products are for laboratory research use only: Not for administration to humans!
Information about the product reference will follow.
more
You will get a certificate here
Viewed